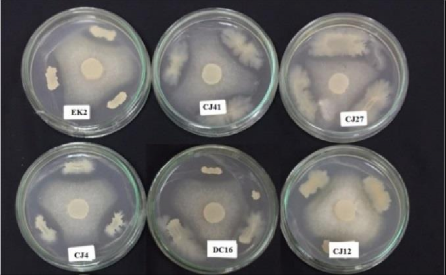
Hình 3 4 Khả năng đối kháng nấm bệnh Fusarium của 6 chủng vi khuẩn vùng rễ 2

không có sự khác biệt về mặt thống kê giữa các nghiệm thức xử lý với các chủng vi khuẩn RB.DS29, RB.BH15và RB.EK2. Khi so sánh chiều dài đoạn thân bị nấm xâm lấn ở nghiệm thức xử lý với các chủng vi khuẩn với đối chứng 2 (đoạn thân hồ tiêu không xử lý vi khuẩn và lây nhiễm nấm) ghi nhận hiệu quả kháng nấm đạt từ 90,97%
- 98,61% (ngoại trừ chủng RB.CJ35 có hiệu quả kháng nấm đạt 0%). Kết quả này cao hơn so với kết quả của Dinu và cộng sự (2007) khi đánh giá khả năng kháng Phytophthora trên đoạn thân hồ tiêu với hiệu quả kháng nấm của 19 chủng phân lập từ 4,7 % đến 77,4%. Trong đó, 10 chủng gây hiệu quả ức chế hơn 50% [122].
Bảng 3.2. Hiệu quả kháng Phytophthora capsici trên đoạn thân hồ tiêu
Chiều dài đoạn thân bị nấm xâm lấn (cm) | Hiệu quả kháng nấm(%) | |
RB.DS29 | 0,11±0,03de | 98,61±0,24a |
RB.BH15 | 0,14±0,05de | 98,19±0,64ab |
RB.EK2 | 0,17±0,05cd | 97,92±0,72ab |
RB.CJ35 | 8,00±0,00a | 0,00±0,00d |
RB.CS1 | 0,31±0,06c | 96,11±0,48b |
RB.CP15 | 0,72±0,1bd | 90,97±1,68c |
RB.EK4 | 0,59±0,13b | 92,64±1,46c |
ĐC 1 | 0,00±0,00a | 100,00±0,00a |
ĐC 2 | 8,00±0,00e | 0,00±0,00d |
P | ** | ** |
CV% | 0,85 | 1,72 |
Có thể bạn quan tâm!
-
Sơ Đồ Bố Trí Thí Nghiệm Tuyển Chọn Chủng Vi Sinh Vật Vùng Rễ Có Khả Năng Kháng Nấm Fusarium Trên Cây Hồ Tiêu Con Trong Điều Kiện Vườn Ươm -
Chương Trình Pha Động Trên Cột C18 -
Quy Trình Phân Tách Các Hợp Chất Vk01, Vk02, Vk03 Và Vk05 -
Ảnh Hưởng Của Chủng Vi Khuẩn Đến Sinh Trưởng Rễ Của Cây Hồ Tiêu Sau 90 Ngày Lây Nhiễm Phytophthora -
Ảnh Hưởng Của Chủng Vi Khuẩn Đến Một Số Chỉ Tiêu Sinh Trưởng Và Kháng Bệnh Của Cây Hồ Tiêu Sau 120 Ngày Lây Nhiễm Nấm Fusarium -
Định Danh Các Chủng Có Tiềm Năng Kháng Phytophthora, Fusarium, Kháng Tuyến Trùng Meloidogyne Gây Bệnh Rễ Ở Cây Hồ Tiêu
Xem toàn bộ 224 trang tài liệu này.
Ghi chú: ĐC 1: Đối chứng không lây nhiễm đoạn thân với Phytophthora; ĐC 2: Đối chứng lây nhiễm đoạn thân với Phytophthora; ** Khác biệt có ý nghĩa thống kê ở mức p<0,01, các chữ cái giống nhau trên cùng một cột thể hiện sự khác biệt không có ý nghĩa thống kê theo trắc nghiệm phân hạng Duncan’s Multiple Rang Test.

Hình 3.3 Chiều dài của đoạn thân hồ tiêu sau 4 ngày lây nhiễm Phytophthora
Như vậy, 3 chủng vi khuẩn RB.DS29, RB.BH15, RB.EK2 có hoạt tính kháng Phytophthora mạnh trên đoạn thân hồ tiêu. Tuy nhiên để tuyển chọn được chủng vi khuẩn có tiềm năng kháng Phytophthora cao nhất trong số 7 chủng vi khuẩn vùng rễ đã tuyển chọn được trong điều kiện invitro, nghiên cứu cần tiến hành đánh giá trên cây hồ tiêu con trong điều kiện vườn ươm.
3.1.1.2. Tuyển chọn các chủng vi khuẩn vùng rễ cây hồ tiêu có tiềm năng kháng nấm Fusarium oxysporum trong điều kiện in vitro
Để tuyển chọn các chủng vi khuẩn có khả năng đối kháng nấm Fusarium sp. gây bệnh chết chậm trên cây hồ tiêu, 269 chủng vi khuẩn vùng rễ phân lập tại 3 tỉnh Tây Nguyên đã được nuôi cấy trên môi trường PGA cùng với nấm Fusarium sp.
Bảng 3.3. Khả năng đối kháng của các chủng vi khuẩn vùng rễ đối với nấm Fusarium trong điều kiện in vitro
Chủng | Rtb(cm) | HSĐK (%) | TT | Chủng | Rtb(cm) | HSĐK(%) | |
1 | RB.DC6 | 3,5 | 12,5±0,07 u | 25 | RB.KN4 | 3,0 | 25,00±0,03o |
2 | RB.DC16 | 2,2 | 43,75±0,05c | 26 | RB.KN5 | 3,0 | 23,75±0,04p |
3 | RB.CP5 | 3,3 | 17,50±0,17s | 27 | RB.KN6 | 3,0 | 23,75±0,04p |
4 | RB.CP12 | 2,5 | 37,50±0,07h | 28 | RB.KN9 | 3,0 | 23,75±0,04p |
5 | RB.CP15 | 2,9 | 26,25±0,01n | 29 | RB.KN10 | 3,4 | 15,00±0,02t |
6 | RB.CP17 | 3,2 | 18,75±0,04r | 30 | RB.CJ1 | 3,4 | 15,00±0,01t |
7 | RB.CS21 | 3,5 | 12,50±0,07u | 31 | RB.CJ2 | 3,5 | 12,50±0,07u |
8 | RB.CS33 | 3,5 | 12,50±0,05u | 32 | RB.CJ3 | 3,5 | 12,50±0,06u |
9 | RB.EK2 | 1,3 | 66,25±0,02a | 33 | RB.CJ4 | 2,3 | 42,50±0,07d |
10 | RB.EK3 | 3,3 | 17,50±0,00s | 34 | RB.CJ10 | 3,5 | 12,50±0,01u |
11 | RB.EK4 | 2,7 | 31,25±0,03k | 35 | RB.CJ12 | 2,3 | 41,25±0,06e |
12 | RB.EK5 | 2,6 | 35,00±0,01j | 36 | RB.CJ13 | 3,5 | 12,50±0,00u |
13 | RB.EK6 | 2,7 | 31,25±0,02k | 37 | RB.CJ27 | 2,1 | 47,50±0,06b |
14 | RB.EK7 | 3,0 | 23,75±0,00p | 38 | RB.CJ32 | 3,4 | 15,00±0,00t |
15 | RB.EK8 | 3,0 | 25,00±0,01o | 39 | RB.CJ41 | 2,2 | 43,75±0,03c |
16 | RB.EK9 | 2,3 | 40,83±0,01f | 40 | RB.DS1 | 2,6 | 35,00±0,09j |
17 | RB.EK10 | 3,1 | 21,25±0,02q | 41 | RB.DS22 | 3,5 | 12,50±0,00u |
18 | RB.EK11 | 2,8 | 30,00±0,01l | 42 | RB.DS28 | 3,0 | 25,00±0,07o |
19 | RB.EK12 | 3,2 | 18,75±0,02r | 43 | RB.DS32 | 3,0 | 23,75±0,05p |
20 | RB.EK13 | 2,5 | 36,25±0,00i | 44 | RB.DL3 | 2,5 | 37,50±0,01h |
21 | RB.EK14 | 2,5 | 36,25±0,01i | 45 | ĐC | 4,0 | 0u |
22 | RB.EK15 | 2,4 | 40,00±0,03g | P | - | ** | |
23 | RB.EK17 | 2,9 | 27,5±0,03m | CV% | - | 0,41 | |
24 | RB.BH14 | 3,5 | 12,50±0,04u |
Ghi chú: R: Bán kính tản nấm Fusarium cấy trên đĩa đối kháng; ĐC: Đĩa nấm bệnh Fusarium; HSĐK: hiệu suất đối kháng; ** Khác biệt có ý nghĩa thống kê ở mức p<0,01, các chữ cái giống nhau trên cùng một cột thể hiện sự khác biệt không có ý nghĩa thống kê theo trắc nghiệm phân hạng Duncan’s Multiple Rang Test.
Qua kết quả trình bày ở bảng 3.3 và quan sát trực tiếp sự phát triển của nấm gây bệnh trên đĩa petri sau 7 ngày nuôi cấy, nghiên cứu tuyển chọn được 44 chủng vi khuẩn có khả năng kháng nấm Fusarium oxysporum với hiệu suất đối kháng đạt từ 12,5% đến 66,25%. Có sự khác biệt về mặt thống kê giữa chủng RB.EK2 so với các chủng còn lại (p<0,01) với hiệu suất đối kháng nấm cao nhất đạt 66,25% gấp 5,3 lần các chủng RB.DC6, RB.CS21, RB.CS33, RB.CJ2, RB.CJ3, RB.CJ10, RB.CJ13,
RB.BH14. Trong đó, 6 chủng có hiệu suất đối kháng nấm cao nhất bao gồm RB.EK2, RB.DC16, RB.CJ4, RB.CJ12, RB.CJ27 và RB.CJ41 với hoạt tính kháng nấm đạt 41,25% đến 66,25% (hình 3.4). Nhìn chung, các chủng vi khuẩn vùng rễ có hoạt tính kháng nấm Fusarium oxysporum được phân lập chủ yếu tại huyện Cư Jut của tỉnh Đắk Nông (4 chủng bao gồm RB.CJ4, RB.CJ12, RB.CJ27 và RB.CJ41).
Hình 3.4. Khả năng đối kháng nấm bệnh Fusarium của 6 chủng vi khuẩn vùng rễ
Kết quả này thấp hơn kết quả nghiên cứu của Nguyễn Thị Kim Cúc và cộng sự (2014) đã tuyển chọn được một số chủng vi khuẩn Bacillus spp. có khả năng kháng nấm Fusarium solani từ 47,52% đến 70,92%, trong đó chủng Bacillus sp. F9 có hoạt tính kháng nấm cao nhất [138]. Tuy nhiên, kết quả kháng nấm trong nghiên cứu này lại cao hơn so với kết quả của Morsy và cộng sự (2009), khả năng kháng nấm Fusarium solani gây bệnh trên cây cà chua của vi khuẩn Bacillus sp. đạt 34,4% [139] và kết quả của Wang và cộng sự (2009) khả năng kháng nấm Fusarium oxysporum của chủng Bacillus licheniformis CHM1 là 51,61% [140]. Có lẽ hiệu quả ức chế Fusarium sp. của các chủng vi khuẩn vùng rễ còn phụ thuộc vào từng loài nấm bệnh
và ký chủ của chúng.
* Trong điều kiện in vivo (trên đoạn thân hồ tiêu)
Đoạn thân hồ tiêu có chiều dài 8 cm (chứa một đốt thân) được xử lý với các chủng vi khuẩn vùng rễ đã được tuyển chọn từ thí nghiệm trước bao gồm RB.EK2, RB.DC16, RB.CJ4, RB.CJ12, RB.CJ27, RB.CJ41 và lây nhiễm với nấm Fusarium sp. để xác định chiều dài đoạn thân bị nấm xâm lấn. Từ đó, tuyển chọn chủng vi khuẩn vùng rễ có hoạt tính kháng nấm bệnh cao trong điều kiện in vivo.
Bảng 3.4. Khả năng kháng nấm Fusarium sp. trên đoạn thân hồ tiêu của 06 chủng vi khuẩn vùng rễ cây hồ tiêu
Chiều dài đoạn thân bị nấm xâm lấn(cm) | Hiệu quả đối kháng (%) | |
RB.EK2 | 1,00±0,19c | 87,5±2,38c |
RB.DC16 | 0,92±0,07c | 88,5±0,87c |
RB.CJ 4 | 0,99±0,11c | 88,5±1,38c |
RB.CJ 12 | 1,33±0,08b | 83,33±1,01c |
RB.CJ 27 | 0,89±0,06c | 88,33±0,72c |
RB.CJ 41 | 0,80±0,07c | 90,00±0,87b |
ĐC1 | 0,00±0,00d | 100,00±0,00a |
ĐC2 | 8,00±0,00a | 0,00±0,00d |
P | ** | ** |
CV% | 5,33 | 1,48 |
Ghi chú: ĐC1: không lây nhiễm đoạn thân với nấm Fusarium; ĐC 2: lây nhiễm đoạn thân với nấm Fusarium; ** Khác biệt có ý nghĩa thống kê ở mức p<0,01, các chữ cái giống nhau trên cùng một cột thể hiện sự khác biệt không có ý nghĩa thống kê theo trắc nghiệm phân hạng Duncan’s Multiple Rang Test.

Hình 3.5. Khả năng kháng nấm Fusarium sp. của 06 chủng vi khuẩn vùng rễ trên đoạn thân hồ tiêu
Kết quả ở bảng 3.4 và hình 3.5 cho thấy, có sự khác biệt về chiều dài đoạn thân
bị nấm xâm lấn và hiệu quả đối kháng nấm ở các nghiệm thức xử lý với các chủng vi khuẩn vùng rễ so với đối chứng ĐC2 (p<0,01). Chiều dài đoạn thân kháng bị nấm xâm lấn ở các nghiệm thức xử lý với vi khuẩn vùng rễ đạt từ 0,8cm – 1,33cm với hiệu quả kháng nấm từ 83,33% - 90,00% và đạt cao nhất ở nghiệm thức xử lý với chủng RB.CJ41. Trong khi đó ở nghiệm thức đối chứng (ĐC2) ngâm đoạn thân trong dịch bào tử nấm bệnh, đoạn thân hồ tiêu bị nấm xâm lấn hoàn toàn (8cm) với hiệu quả kháng nấm là 0%.
3.1.1.3. Tuyển chọn các chủng vi khuẩn vùng rễ có tiềm năng kháng tuyến trùng trong điều kiện in vitro
Sau khi sàng lọc sơ bộ các chủng đã phân lập tại Đắk Lắk, Đắk Nông và Gia Lai, nghiên cứu đã tuyển chọn được 43 chủng vi khuẩn vùng rễ có hoạt tính kháng tuyến trùng. Xây dựng phương trình tương quan giữa mật độ tế bào vi khuẩn và giá trị OD610nm của 43 chủng để tuyển chọn các chủng có khả năng kháng tuyến trùng cao trong điều kiện in vitro.
Kết quả ghi nhận ở bảng 3.5 cho thấy, tỷ lệ tử vong tuyến trùng của 43 chủng vi khuẩn vùng rễ phân lập tại 3 tỉnh Tây Nguyên đạt từ 73% đến 96,33% với 6 chủng vi khuẩn vùng rễ có tỷ lệ tử vong tuyến trùng Meloidogyne sp. cao nhất đạt từ 91,33 đến 96,33% bao gồm 3 chủng phân lập tại Đắk Lắk là RB.EK7, RB.BH11, RB.EK2, 02 chủng phân lập tại Đắk Nông là RB.DS33, RB.CJ4 và 01 chủng phân lập tại tỉnh Gia Lai là RB.CS30. Trong đó, chủng RB.EK7 có tỷ lệ tử vong tuyến trùng cao nhất gấp 1,01 lần đến1,41 lần so với các chủng còn lại. 6 chủng này được lựa chọn cho nghiên cứu đánh giá tiềm năng kháng tuyến trùng của các chủng vi khuẩn vùng rễ trong điều kiện vườn ươm.
Sáu chủng tuyển chọn có hoạt tính kháng tuyến trùng cao hơn nghiên cứu của Ann và cộng sự (2013) đã phân lập được 4 chủng vi khuẩn vùng rễ có hoạt tính kháng tuyến trùng tại các vườn trồng hồ tiêu ở Malaysia [141]. Trong số các chủng này, hai chủng Bacillus spp MPB04 và MPB93 có hoạt tính kháng tuyến trùng lần lượt đạt 76,4 và 50,6%, có thể tiêu diệt tuyến trùng trong vòng 2 giờ và phá hủy hoàn toàn tuyến trùng trong vòng 12 giờ. Tuy nhiên, khả năng ức chế tuyến trùng M. incognita J2 của 6 chủng này lại thấp hơn 3 chủng B. megaterium, A. radiobacter và C. davisae đạt 98,3%, 97,3% và 94,6% trong nghiên cứu của Mekete và cộng sự (2009) khi đánh giá ảnh hưởng của dịch lọc từ vi khuẩn vùng rễ cây cà phê kháng tuyến trùng Meloidogyne incognita [142]. Kết quả nghiên cứu của chúng tôi cũng cao hơn so với Nguyễn Thị Hạnh và cộng sự (2019) tiến hành nghiên cứu hoạt tính đối kháng tuyến trùng Meloidogyne incognita của vi khuẩn vùng rễ cây hồ tiêu [143]. Kết quả cho
thấy, 3 chủng vi khuẩn BMT10, BMT11, BMT15 có hoạt tính đối kháng cao với tỷ lệ tử vong của tuyến trùng lần lượt đạt 81,67%, 98,33%, 88,33%.
Bảng 3.5. Tỷ lệ tử vong tuyến trùng của 43 chủng vi khuẩn vùng rễ
Chủng | Tỷ lệ tử vong (%) | STT | Chủng | Tỷ lệ tử vong (%) | |
1 | RB.EK1 | 73±0,06jk | 25 | RB.DS5 | 81,00±0,11c-j |
2 | RB.EK2 | 91,33±0,01a-c | 26 | RB.DS9 | 83,00±0,06c-j |
3 | RB.EK4 | 88,33±0,06a-f | 27 | RB.DS10 | 85,00±0,11a-i |
4 | RB.EK7 | 96,33±0,02a | 28 | RB.DS11 | 87,33±0,01a-h |
5 | RB.EK9 | 90,33±0,02a-d | 29 | RB.DS16 | 84,00±0,01b-j |
6 | RB.EK10 | 90,33±0,07a-d | 30 | RB.DS18 | 78,67±0,08e-k |
7 | RB.EK12 | 78,67±0,06e-k | 31 | RB.DS19 | 77,00±0,06f-k |
8 | RB.KN3 | 90,33±0,02a-d | 32 | RB.DS20 | 85,67±0,05a-i |
9 | RB.KN5 | 74,67±0,12i-k | 33 | RB.DS33 | 91,33±0,04a-c |
10 | RB.KN6 | 88,00±0,03a-h | 34 | RB.DL3 | 82,67±0,03c-j |
11 | RB.KN7 | 76,00±0,13h-k | 35 | RB.CJ4 | 95,00±0,04ab |
12 | RB.KN8 | 83,67±0,10 b-j | 36 | RB.CS5 | 87,33±0,05a-h |
13 | RB.KN10 | 78,67±0,05e-k | 37 | RB.CS6 | 76,67±0,06g-k |
14 | RB.KN11 | 85,00 ±0,01a-i | 38 | RB.CS7 | 81,00±0,07c-j |
15 | RB.KN12 | 68,33±0,11k | 39 | RB.CS22 | 83,33±0,04c-j |
16 | RB.BH3 | 90,00±0,04a-e | 40 | RB.CS25 | 83,00±0,05c-j |
17 | RB.BH6 | 88,00±0,03a-g | 41 | RB.CS30 | 91,33±0,02a-c |
18 | RB.BH7 | 78,00±0,14f-k | 42 | RB.DC12 | 83,33±0,02c-j |
19 | RB.BH8 | 78,33±0,03f-h | 43 | RB.DC13 | 84,33±0,02b-j |
20 | RB.BH11 | 91,67±0,05a-c | 44 | ĐC nước | 8,00±0,02m |
21 | RB.BH13 | 79,00±0,06d-k | 45 | ĐC mt | 29,33±0,04l |
22 | RB.BH14 | 80,33±0,02c-j | P | ** | |
23 | RB.DS1 | 90,67±0,03a-c | CV% | 6,67 | |
24 | RB.DS2 | 77,00±0,03f-k |
Ghi chú: ĐC: đối chứng; mt: Môi trường; ** Khác biệt có ý nghĩa thống kê ở mức p<0,01, các chữ cái giống nhau trên cùng một cột thể hiện sự khác biệt không có ý nghĩa thống kê.
Kết luận chung: từ 269 chủng vi khuẩn đã phân lập từ vùng rễ cây hồ tiêu tại 3 tỉnh Tây Nguyên, nghiên cứu đã tuyển chọn được 7 chủng vi khuẩn RB.BH15,
RB.EK2, RB.CP15, RB.CJ35, RB.CS1,RB.EK4 và RB. DS29 kháng Phytophthora
capsici cao nhất với hiệu suất đối kháng đạt từ 62,67% đến 65,33%; 6 chủng vi khuẩn có hoạt tính kháng nấm Fusarium oxysporum bao gồm RB.EK2, RB.DC16, RB.CJ4, RB.CJ12, RB.CJ27 và RB.CJ41 với hoạt tính kháng nấm đạt 41,25% đến 66,25%; 6 chủng vi khuẩn vùng rễ có hoạt tính kháng tuyến trùng cao nhất bao gồm RB.EK7, RB.CJ4, RB.EK2, RB.DS33, RB.BH11, RB.CS30 với hoạt tính kháng tuyến trùng trên 90%. Các chủng này được sử dụng cho nghiên cứu tuyển chọn các chủng vi khuẩn vùng rễ cây hồ tiêu có tiềm năng kháng Phytophthora capsici, Fusarium oxysporum, tuyến trùng Meloidogyne gây bệnh rễ ở cây hồ tiêu trong điều kiện vườn ươm nhằm đánh giá ảnh hưởng của các chủng vi khuẩn vùng rễ đến sinh trưởng cũng như các chỉ tiêu về bệnh trên cây hồ tiêu vườn ươm từ đó tuyển chọn được chủng có tiềm năng kháng cao nhất ứng dụng trong nghiên cứu sản xuất chế phẩm sinh học kiểm soát bệnh hại rễ trên cây hồ tiêu.
3.1.2. Tuyển chọn các chủng vi khuẩn vùng rễ cây hồ tiêu có tiềm năng kháng Phytophthora, Fusarium, tuyến trùng Meloidogyne gây bệnh rễ ở cây hồ tiêu trong điều kiện vườn ươm
3.1.2.1. Tuyển chọn các chủng vi khuẩn vùng rễ có tiềm năng kháng Phytophthora capsici trong điều kiện vườn ươm
* Ảnh hưởng của chủng vi khuẩn vùng rễ đến sinh trưởng của cây hồ tiêu
Sinh trưởng của cây là một chỉ tiêu quan trọng để đánh giá khả năng kiểm soát bệnh của các chủng vi khuẩn. Cây hồ tiêu có khả năng sinh trưởng mạnh chứng tỏ khả năng ức chế nấm bệnh càng cao của chủng vi khuẩn. Sau 90 ngày lây nhiễm với nấm bệnh, cây hồ tiêu trong bầu được được đo các chỉ tiêu về sinh trưởng (Bảng 3.6).
Đối với các chỉ tiêu sinh trưởng về lá và thân cây hồ tiêu, kết quả thể hiện ở bảng 3.6 cho thấy, các chủng vi khuẩn tuyển chọn đều tác động lên số lá tăng từ 44,98% đến 190,33% so với đối chứng ĐC1 và ĐC2. Trong các nghiệm thức xử lý vi khuẩn, số lá/cây hồ tiêu có sự khác biệt có ý nghĩa thống kê (p<0,01) ở nghiệm thức RB.DS29 so với các nghiệm thức RB.CJ35, RB.EK2, RB.CP15, RB.CS1. Số lá gấp 1,38 lần đến 2,9 lần được thể hiện thông qua số lá nhiều, to, cứng cáp hơn. Tuy nhiên, không có sự khác biệt về mặt thống kê giữa các nghiệm thức RB.EK4 (6,67 lá), RB.BH15 (7 lá) và ĐC1 (6,67 lá).
Bên cạnh số lá, diện tích lá cây hồ tiêu có sự khác biệt về mặt thống kê (p<0,01) giữa nghiệm thức RB.EK2 và RB.BH15 so với các nghiệm thức còn lại. Diện tích lá
đạt thấp nhất ở nghiệm thức đối chứng ĐC2 (1367,3mm2) và cao nhất ở nghiệm thức RB.EK2 đạt 2372 mm2. Ở các nghiệm thức còn lại, diện tích lá tăng từ 15,94% đến 73,48% so với đối chứng ĐC2.
Bảng 3.6. Ảnh hưởng của chủng vi khuẩn đến sinh trưởng thân, lá của cây hồ tiêu sau 90 ngày lây nhiễm Phytophthora capsici
Số lá/ dây tiêu | Diện tích lá (mm2) | Đường kính thân (mm) | Khối lượng tươi (g) | Chlorophyll (mg/g) | ||
a | b | |||||
RB.EK4 | 6,67±0,62ab | 1891,30±116,33bc | 3,40±0,20a | 8,85±2,51a-c | 0,35±0,07cd | 0,28±0,09ab |
RB.CJ35 | 5,67±1,60b | 1705,00±74,48cd | 3,26±0,19ab | 7,47±01,81bc | 0,35b±0,01cd | 0,21±0,06bc |
RB.EK2 | 6,00±1,60b | 2372,00±288,02a | 3,23±0,09ab | 8,61±1,72a-c | 0,46±0,07a | 0,37±0,03a |
RB.CP15 | 5,67±2,61b | 1585,30±96,29de | 3,30±0,14b | 7,47±1,95bc | 0,33±0,07d | 0,28±0,02a-c |
RB.DS29 | 9,67±,1,50a | 2026,70±91,59b | 3,23±0,14ab | 10,99±1,26a | 0,44±0,01a | 0,32±0,03ab |
RB.CS1 | 5,67±1,23b | 1640,30±140,38cd | 3,23±0,21ab | 6,15±1,09cd | 0,42±0,02a-c | 0,29±0,03abc |
RB.BH15 | 7,00±0,43ab | 2141,30±131,69ab | 3,40±0,10a | 8,43±0,80a-c | 0,43±0,02ab | 0,28±0,01ab |
ĐC 1 | 6,67±0,96ab | 2026,30±121,22b | 3,30±0,11b | 9,55±0,79ab | 0,32±0,01d | 0,22±0,02bc |
ĐC2 | 3,33±1,94b | 1367,30±168,01e | 3,06±0,17b | 5,44±0,92c | 0,30±0,02d | 0,17±0,04c |
P | ** | ** | ** | * | ** | ** |
CV% | 22,17 | 8,40 | 3,69 | 23,48 | 8,52 | 17,14 |
Ghi chú: ĐC 1: Đối chứng không lây nhiễm đoạn thân với Phytophthora; ĐC 2: Đối chứng lây nhiễm đoạn thân với Phytophthora. * Khác biệt có ý nghĩa thống kê ở mức p<0,05;
** Khác biệt có ý nghĩa thống kê ở mức p<0,01, các chữ cái giống nhau trên cùng một cột thể hiện sự khác biệt không có ý nghĩa thống kê theo trắc nghiệm phân hạng Duncan’s Multiple Rang Test
Ngoài ra, các chủng vi khuẩn vùng rễ cũng tác động đến đường kính thân và trọng lượng thân tươi của cây hồ tiêu và có sự khác biệt về mặt thống kê giữa các nghiệm thức thí nghiệm. Khi so sánh các nghiệm thức lây nhiễm nấm và xử lý vi khuẩn với đối chứng lây nhiễm nấm không xử lý vi khuẩn (ĐC2), đường kính cây hồ tiêu gấp 1,05 lần đến 1,11 lần. Trong đó, nghiệm thức xử lý RB.EK4 và RB.BH15 cây hồ tiêu có đường kính thân cao nhất đạt 3,4mm và khác biệt có ý nghĩa so với nghiệm thức ĐC2 ở mức p<0,01. Tuy nhiên, cây hồ tiêu ở nghiệm thức RB.DS29 lại có khối lượng tươi cao nhất tăng 102,02% so với cây hồ tiêu ở nghiệm thức ĐC2. Ở các nghiệm thức còn lại khối lượng thân tươi tăng từ 13,05% đến 62,68% (Bảng 3.6). Khi đánh giá hàm lượng Chlorophyll (mg/g) trong lá cây hồ tiêu vườn vươm cũng cho thấy, giữa các nghiệm thức có sự khác biệt có ý nghĩa thống kê ở mức






